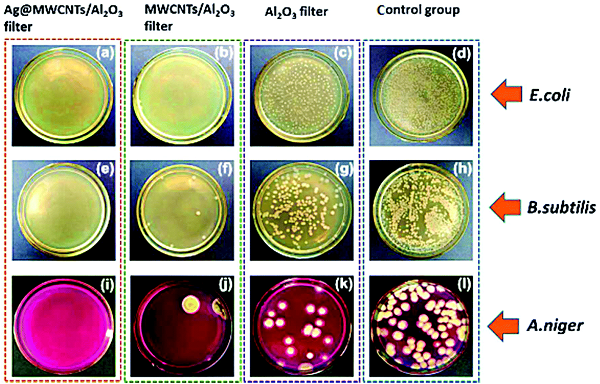

【引言】
近年来,空气污染问题备受关注。对于室内空气污染的治理成为当下的研究热点之一。室内空气污染具有累积性,长期性和多样性的特点。除了人们熟知的PM2.5,挥发性有机物、细菌等也是室内空气的主要污染源。目前,对空气中各种污染物的控制,主要采用分步处理模式,通常采用多层滤网串联来实现PM2.5捕捉、甲醛去除等目的。分步处理不仅占用更多空间,而且投资和维护费用高。因此,发展以多功能净化材料为基础的一体化控制技术是解决上述问题的关键。
【成果简介】
南京工业大学仲兆祥教授团队以多孔陶瓷材料为基体,在其颗粒堆积孔道口生长碳纳米管,随后在碳纳米管上均匀沉积纳米银颗粒,形成以微米孔道、碳纳米管和纳米催化组分构成的多层次结构膜材料。高孔隙膜基体具有三维联通的孔道结构,透气性好;纳米纤维组成的拦截网络显著提高了粉尘扩散与惯性撞击概率,且由于纤维尺度与气体分子平均自由程相当,诱导产生滑移流效应,使纤维表面的气体曳力低于非滑移流下的曳力,几乎不影响膜孔道阻力;多层次孔道结构具有较大的比表面积,是良好的催化剂载体,高度分散的纳米催化剂具有优越的催化性能,可快速降解VOCs。该膜对空气中纳米粉尘的截留率达到100%,远超过HEAP滤网国际标准(对直径为0.3微米的微粒去除率需达到99.97%),同时大幅降低过滤压降,降低了空气净化能耗,计算表明该膜具有较高的质量因子(Quality Factor),同时对革兰氏阴性菌、革兰氏阳性菌、真菌等具有良好的抑制效果,在室温下对甲醛有82.2%的一次降解率。相关研究成果发表在Nanoscale上(Nanoscale, 2017,9, 5433-5444),并被选为外封面论文。
【图文导读】

纳米“珍珠项链”构型Ag@MWCNTs

(a) 多功能催化抑菌过滤膜的制备过程示意图;
(b-d) 多孔Al2O3陶瓷膜表面形貌;
(e-g) Ag@MWCNTs/Al2O3表面形貌;
(h) AgNPs@MWCNTs的元素分布情况.

(a)不同样品对三种细菌的动态截留性能比较;
(b) 实验室条件下,不同样品的抑菌性能比较;
(c) 真实环境下,不同样品的的动态抗菌性能比较;
(d)样品对甲醛的降解性能比较;
(e) MWCNT/Al2O3和Ag@MWCNTs/Al2O3对甲醛的降解效果对比;
(f-g) 截留率和压降的变化
(h-i) 截留率和品质因子随过滤速度的变化.
(a-d)大肠杆菌(E. coli), (e-h) 枯草芽孢杆菌(B.subtilis), 黑曲霉菌(A.niger)表征的不同样品的动态抗菌效果对比;(a,e,i)为Ag@MWCNTs/Al2O3, (b,f,j)为MWCNTs/Al2O3, (c,g,k)为Al2O3, (d,h,l)为空白样.
【小结】
本研究提供了一种基于多层次微纳米结构的构建设计功能膜材料的思路,其核心在于材料中不同尺度与功能单元间的有机结合与协同作用。研究工作实现了空气净化材料从单一的PM2.5去除到VOCs、细颗粒物(PM2.5)、细菌等多种污染物的协同控制的拓展,对空气污染物控制模式的革新具有一定借鉴意义。
文献链接:Multifunctional hybrid porous filters with hierarchical structures for simultaneous removal of indoor VOCs, dusts and microorganisms(Nanoscale,2017,DOI:10.1039/C6NR09779K)
本文由材料人Allen整理。
材料牛网专注于跟踪材料领域HTH官网地址 及行业进展,这里汇集了各大高校硕博生、一线科研人员以及行业从业者,如果您对于跟踪材料领域HTH官网地址 进展,解读高水平文章或是评述行业有兴趣,点我加入编辑部大家庭。
欢迎大家到材料人宣传HTH官网地址 成果并对文献进行深入解读,投稿邮箱tougao@cailiaoren.com。
投稿以及内容合作可加编辑微信:xiaofire-18,吴玫,我们会拉各位老师加入专家群。





